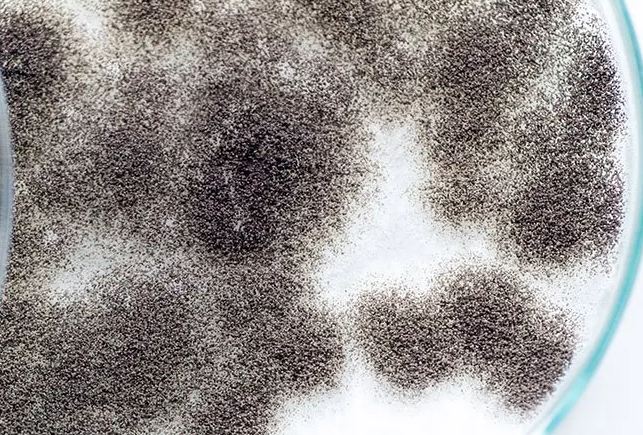

Everyday life can hold hidden surprises objects or scenes that look entirely ordinary until something unexpected draws attention. Recently, people have shared images and stories of everyday items that startled them by their appearance. Below is a look at eleven of these astonishing discoveries, exploring how common things can suddenly seem extraordinary.
1. Multicolored Corn
One individual found three ears of corn from the same patch, yet each bore wildly different hues. One ear showed stripes of orange, green, brown, and purple; another held patches of pink and yellow; and the third was marbled in shades of black and purple. The result looked more like artwork than a vegetable.

2. Frosted Petal Paintings
After an early frost, coneflowers in one garden looked as though they had been encased in ice sculptures. The delicate petals were frozen mid-bloom, creating the illusion of a crystalline painting formed overnight. What is ordinarily fluid and soft became solid and frozen in an instant.
3. Purple Cedarwood Core
While splitting logs in a forest, someone exposed the inner grain of a piece of cedar that glowed with a purple-pink tone. On the surface, the wood looked normal, but inside was a vibrant hue that looked nearly painted. Nature’s subtle surprises can sometimes reveal hidden beauty where least expected.
4. Towering Sunflower
One garden grew a sunflower that reached nearly twice the height of its gardener. Standing beside it, the plant towered impressively high, making the observer question whether it was truly a tree rather than a flower. Its stem seemed to stretch skyward in a remarkable display of growth.
5. Alien Lemon
In an unexpected twist, a backyard lemon developed bumpy protrusions that made it look like an alien creature. The fruit‘s skin bulged in odd ways, almost revealing its inside, with shapes and contours unlike any typical lemon. It was unlike anything the gardener had ever seen.
6. Spoon Handle Filled with Sand
During meal preparation, a serving spoon broke—and in its hollow handle lay sand. As it fractured, sand poured into the food, ruining the dish. A utensil meant for cooking hiddenly doubled as a container, turning a kitchen tool into a curiosity.
7. Blue Toilet Seat
One expectant couple noticed that their padded toilet seat shifted hues, appearing a deep blue. Although the mechanism behind the change isn’t clear, colored sweating (in rare cases) or other unusual physiological processes have been known to tint surfaces in contact with the skin.
8. Giant Penne Pasta
A pasta box held a surprise when a single penne noodle rivaled the size of the box itself. Instead of the usual small tube, this giant version looked almost laughably oversized. It’s a manufacturing fluke that turned dinner prep into a moment of astonishment.
9. Spaghetti Wrapped in Mold
A plate of leftover spaghetti was left in a microwave, only to be rediscovered days later under a cottony dome of mold. The growth was so substantial it hid the noodles entirely, creating a bizarre mushroom-like structure where pasta once lay.
10. Unusual Pizza Slicing
One father refused to cut his pizza using traditional triangles or squares. Instead, he devised a slicing pattern that avoided cutting through pepperoni, leaving each slice oddly shaped so that no topping was cut in half. The result was less geometric but more respectful of the toppings.
11. (Bonus) Unexpected Object Camouflage
Beyond these specific instances, many shared snapshots where everyday items—rocks, walls, fruit—turned out to be misleading. Shadows, patterns, or rare genetic variations caused surfaces to resemble animals, faces, or scenes you wouldn’t expect on first glance.
















